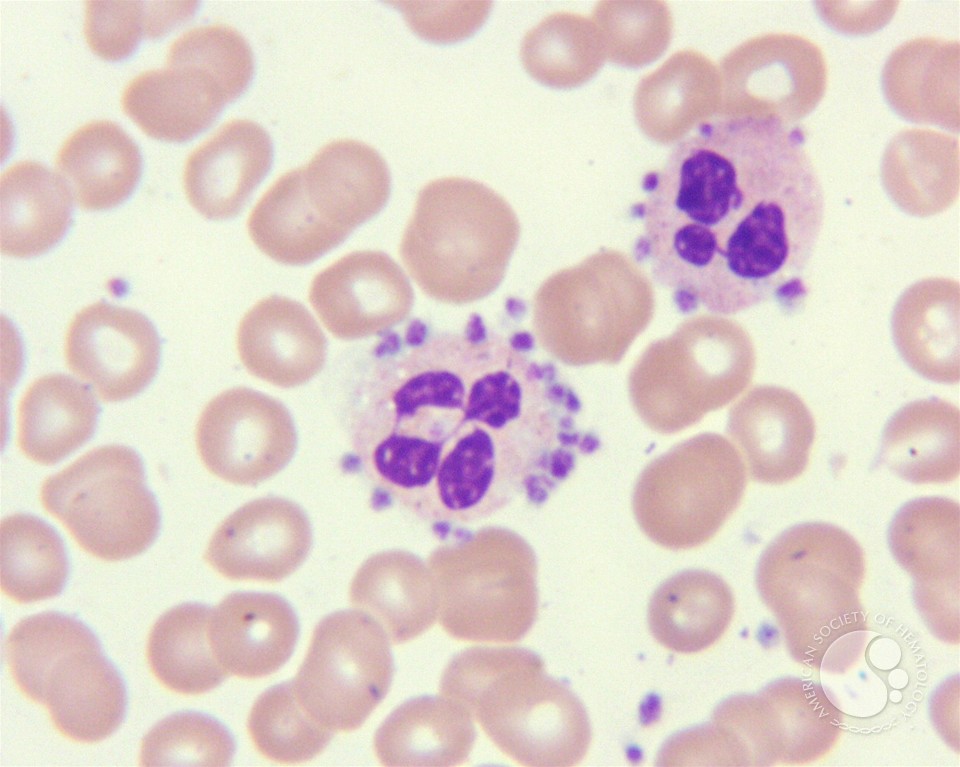
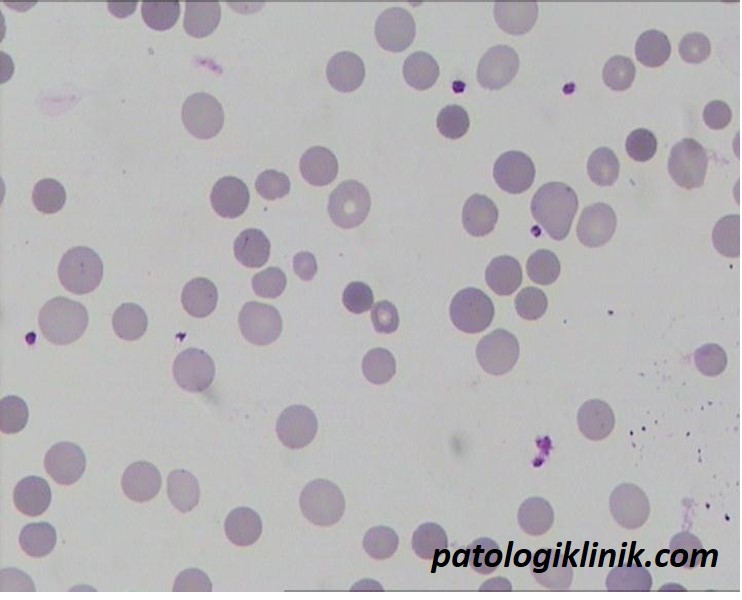
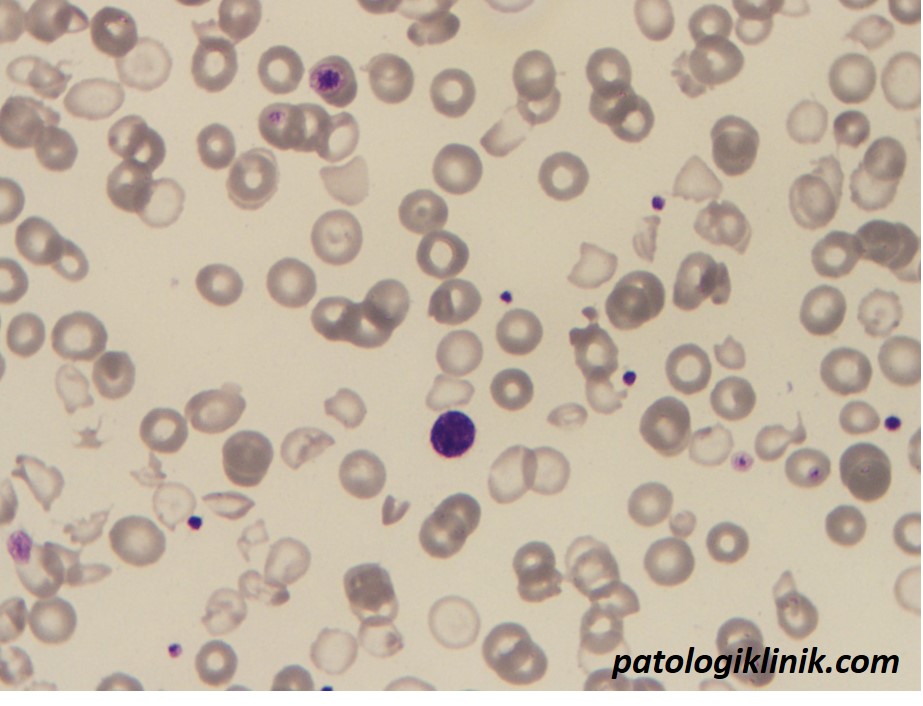

Kesalahan-kesalahan pada Hitung Trombosit Otomatis

Perubahan hitung trombosit, baik turun atau meningkat, sangat mempengaruhi penatalaksanaan pada suatu penyakit. Perubahan ini bisa benar-benar terjadi atau bisa juga palsu. Di era otomatisasi pemeriksaan hematologi, walau meningkatkan akurasi dan presisi hasil laboratorium, juga memunculkan berbagai masalah hasil laboratorium yang palsu, termasuk hitung trombosit.
Trombositopenia palsu seringkali ditemukan terutama pada pasien bayi karena kesulitan pengambilan spesimen dan bekuan parsial akibat homogenisasi vakutainer yang kurang adekuat. Sedangkan keadaan trombositosis palsu lebih jarang ditemukan, pada umumnya terjadi pada keadaan mikrositosis berat dan fragmentosit.
Berikut beberapa penyebab hitung trombosit otomatis rendah palsu:
- bekuan parsial pada spesimen
- aktivasi trombosit selama pungsi vena yang diikuti agregasi
- aktivasi trombosit selama operasi bypass kardiopulmonar
- agregasi trombosit yang diinduksi EDTA (tampak lebih sering pada infeksi virus, khususnya hepatitis A, CMV, dan influenza A)
- degranulasi dan pembengkakan trombosit yang diinduksi EDTA
- clumping trombosit
- fagositosis trombosit oleh netrofil dan monosit
- penyimpanan darah pada suhu 4oC selama lebih dari 24 jam
- trombosit raksasa yang jatuh di atas ambang atas untuk hitung trombosit

Beberapa penyebab hitung trombosit otomatis tinggi palsu:
- fragmen eritrosit yang jatuh di bawah ambang atas hitung trombosit
- mikrosferosit pada sferositosis herediter
- mikrosferosit pada luka bakar
- pemanasan spesimen darah yang tidak disengaja
- fragmen leukosit yang terhitung sebagai trombosit (fragmen sel blast, sel hairy, atau sel limfoma)
- penyakit HbH
- krioglobulin
- hipertrigliseridemia atau hiperlipidemia
- penggunaan emulsi perfluorokarbon
- bakteri dalam spesimen darah, baik pada pasien dengan bakteremia atau karena penundaan pemrosesan dalam iklim panas
- jamur seperti Candida dalam spesimen darah, seringkali pada jalur infus yang lama
- eritrosit yang mengandung parasit malaria
- partikel bukan trombosit dalam konsentrat trombosit

Semoga bermanfaat.
Sumber:
Pedoman Pemeriksaan Hematologi. PDS Patklin.




![[Download] Pedoman Nasional Pelayanan Kedokteran Tata Laksana Thalassemia (KMK)](/content/images/uploads/2022/10/KMK.jpg)
![[Download] Pemeriksaan Laboratorium pada Thalassemia](/content/images/uploads/2022/09/cover-web-scaled.jpg)